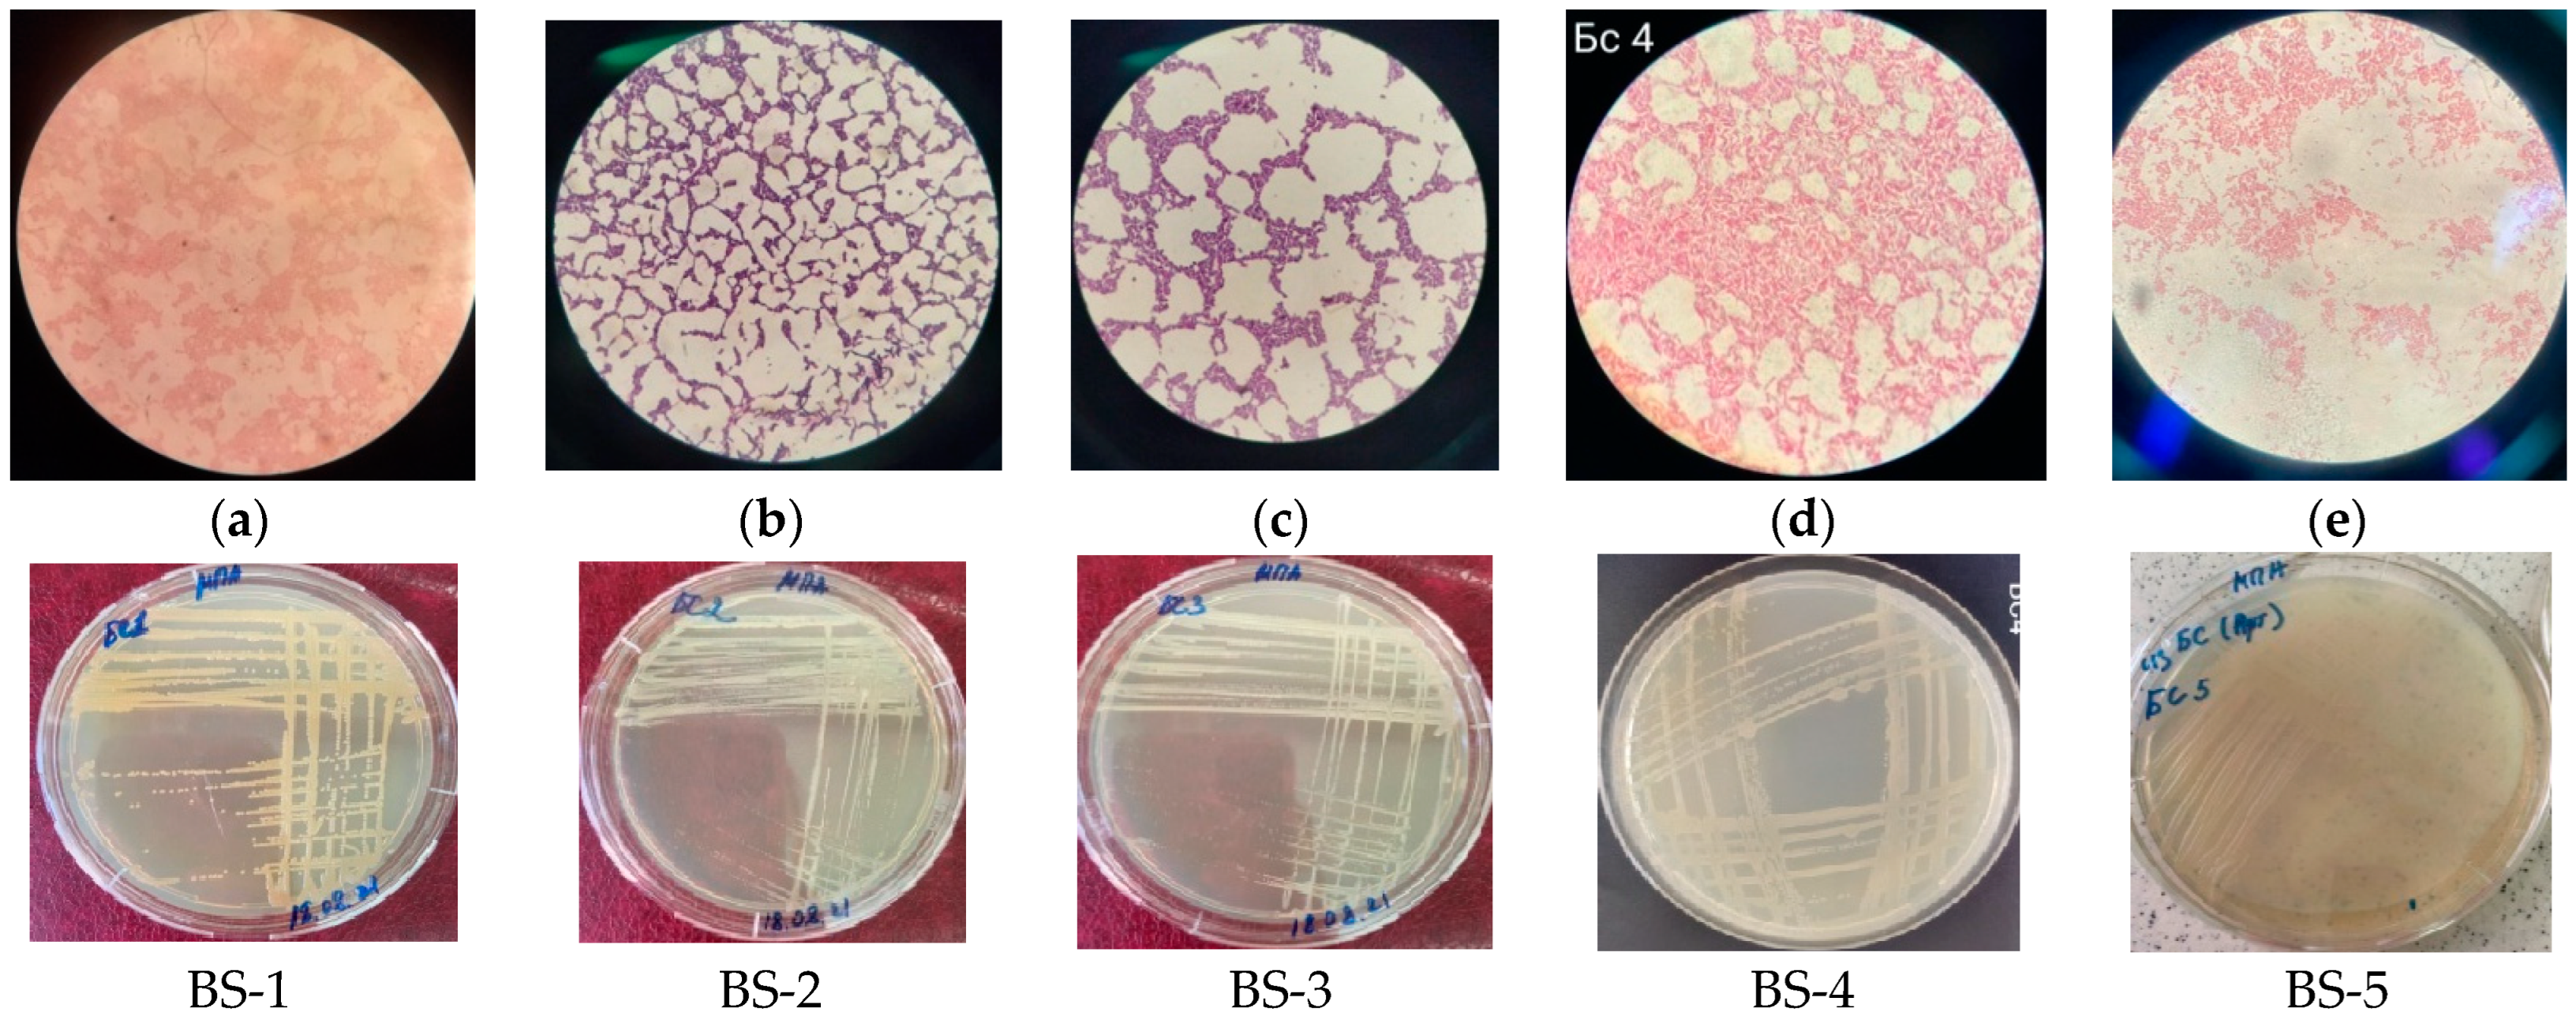
Sustainability 15 00051 g001
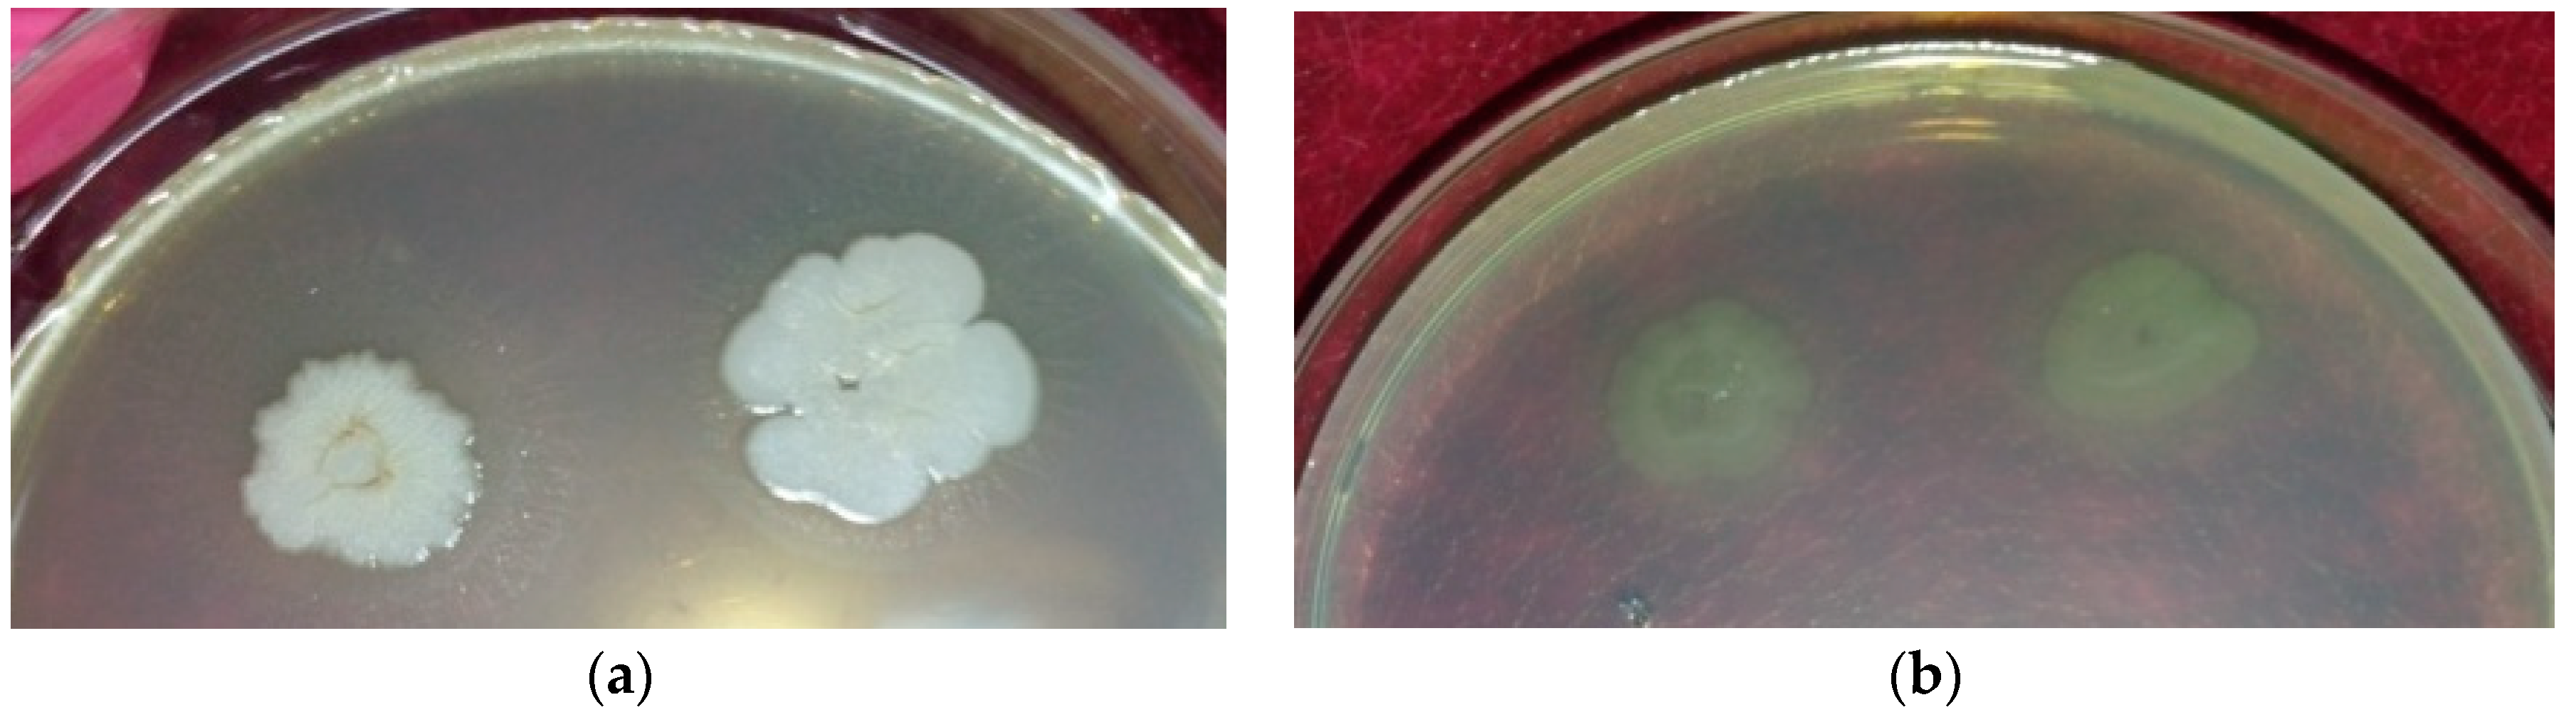
Sustainability 15 00051 g003
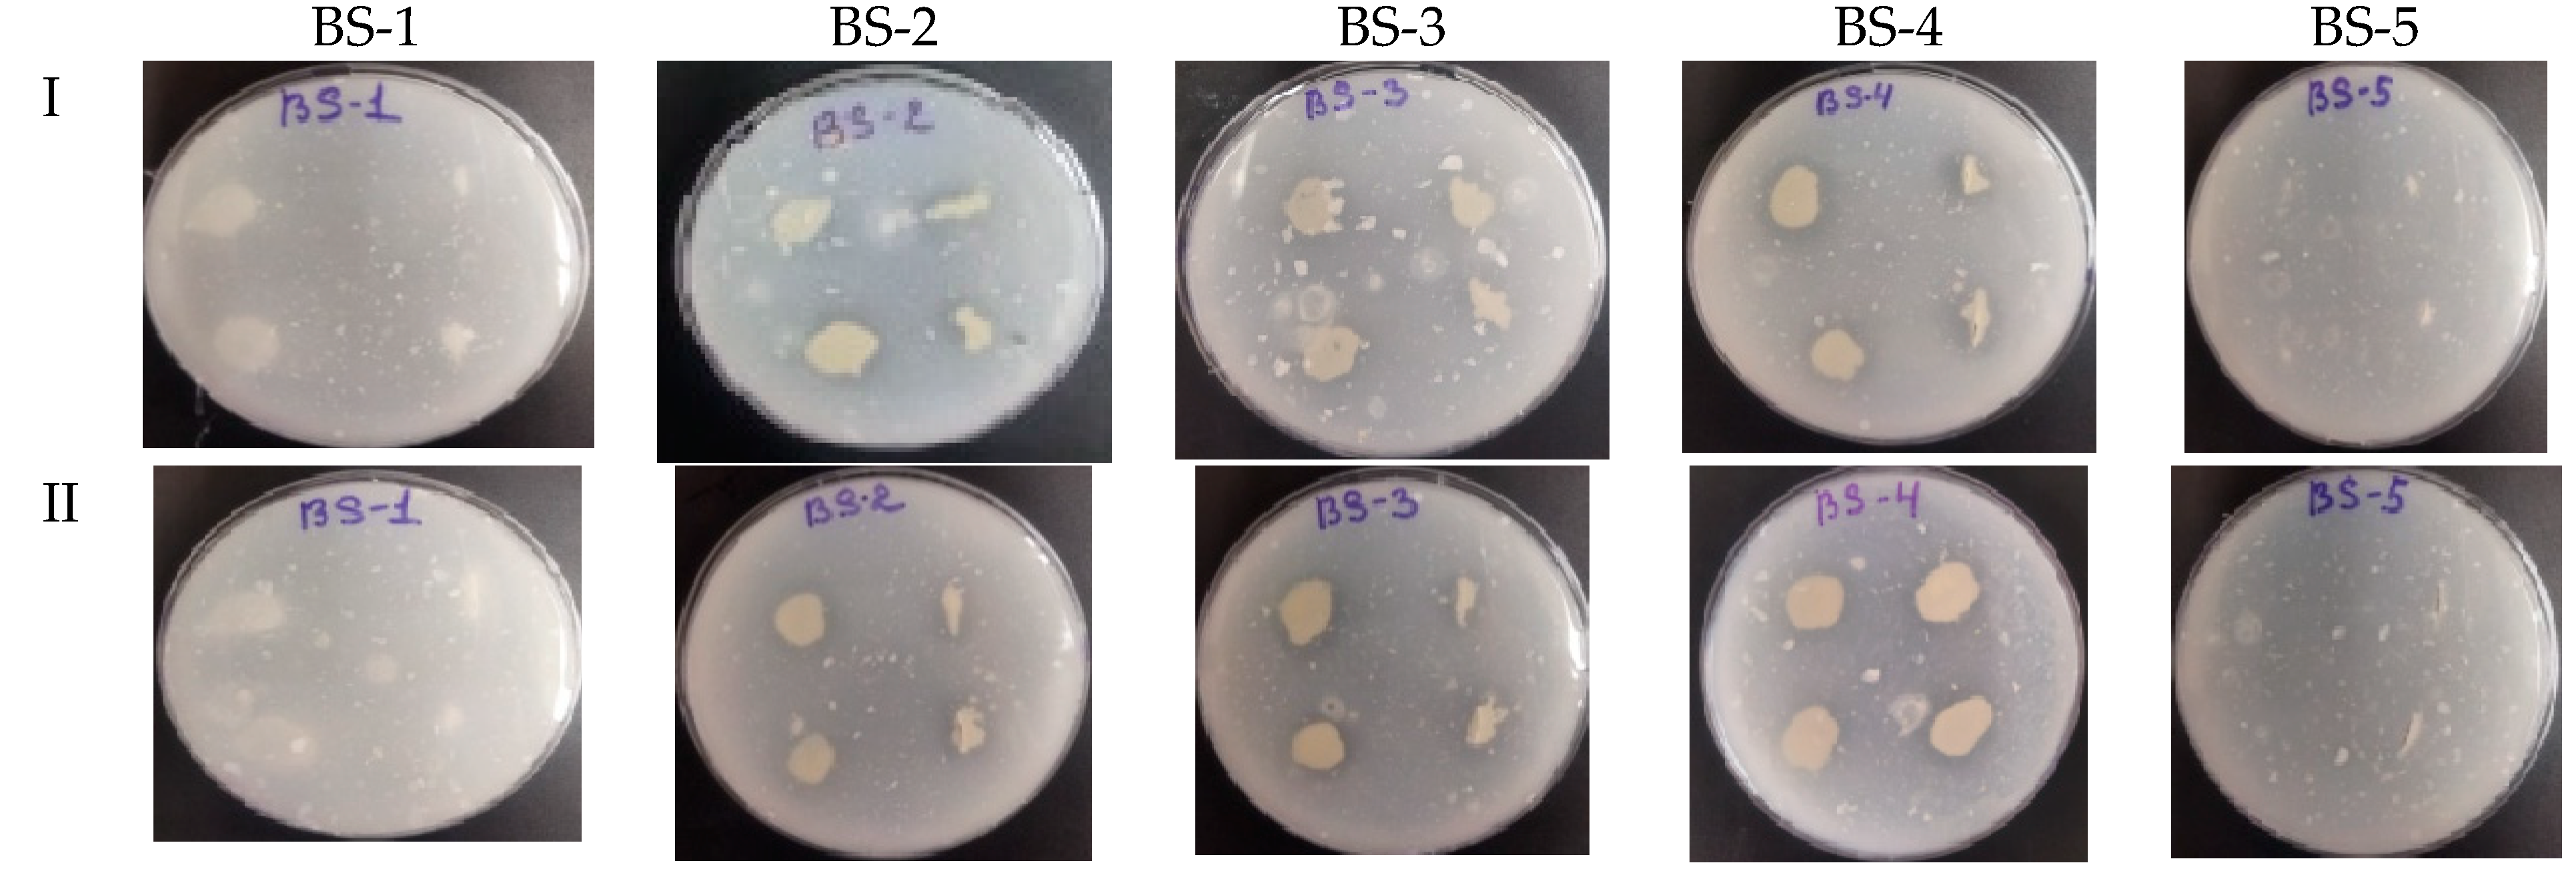
Sustainability 15 00051 g005
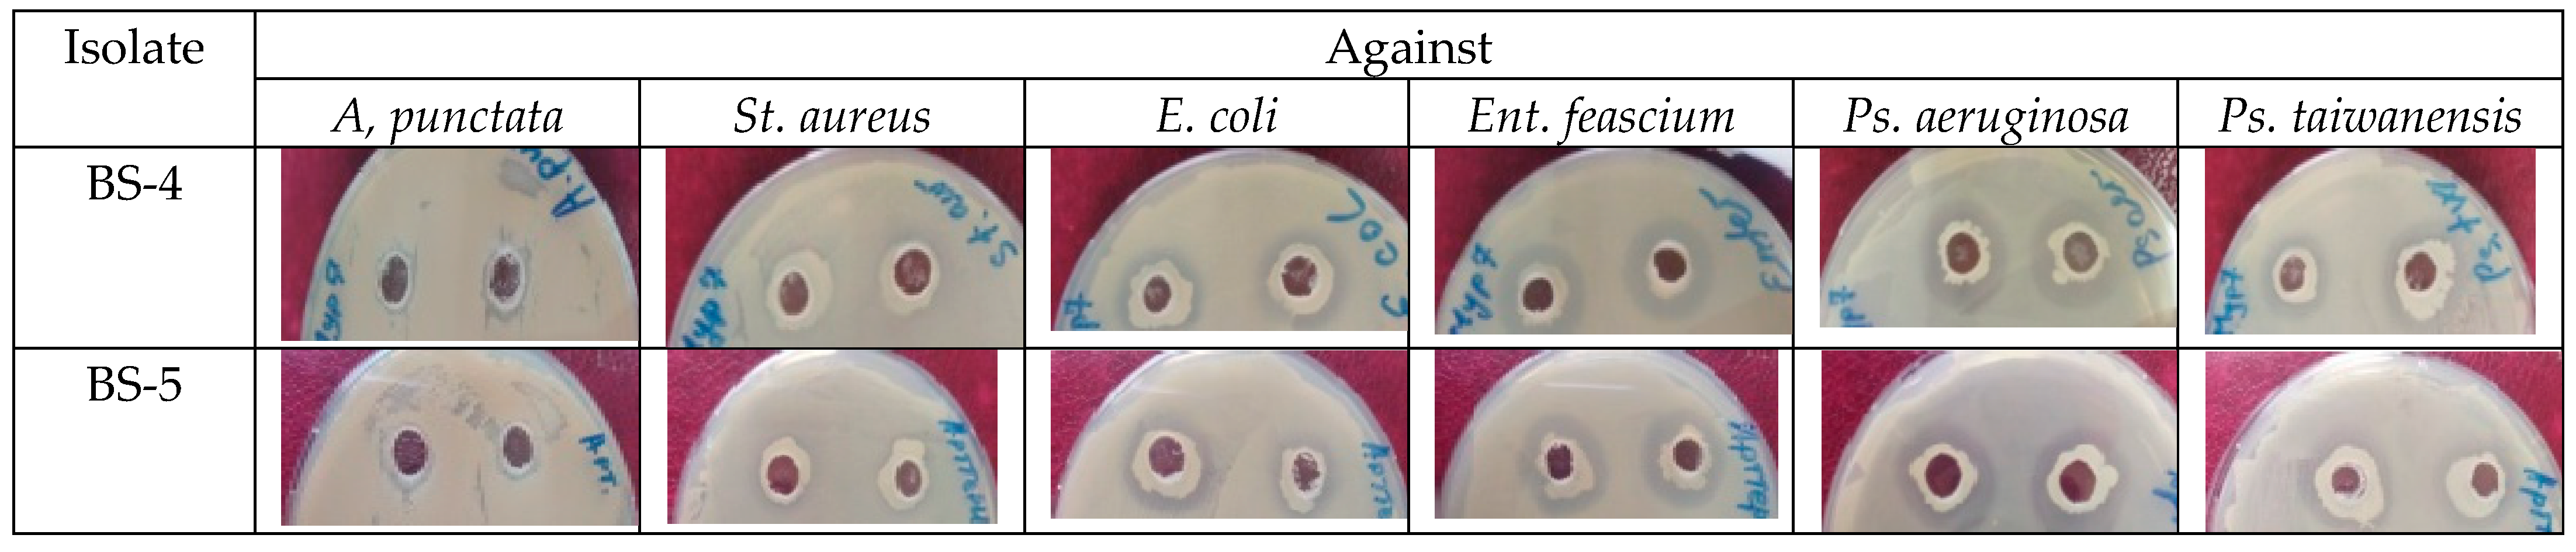
Sustainability 15 00051 g006

1. Introduction
A number of water pollution issues are largely caused by wastewater effluents. The majority of developing nations’ cities produce 30–70 mm
3 of wastewater per person annually [
1]. Because the facilities are insufficient or they are not up to standard, wastewater and its effluents are frequently dumped into surface water sources, which serve as disposal sites for both home and commercial waste [
2]. The receiving surface water body quality deteriorates as a result of the wastewater effluents’ poor quality [
3,
4]. To reduce the risk to the aquatic ecosystem and users of surface water resources, wastewater effluent must be treated effectively before discharge. However, finding relatively low-cost and effective treatment systems is still a worldwide concern [
5,
6,
7,
8].
One of the problems of wastewater pollution is phosphates, in particular polyphosphates, which adversely affect human health and the environment. Modern manufacturers use polyphosphates in the food industry as dough leavening agents, stabilizers, emulsifiers, and moisture retainers, as well as in water purification systems, in the manufacture of household chemicals to soften water, degrease fibers, and slow down corrosion. In food products, polyphosphates are of low toxicity, but if they accumulate in large quantities in the environment, they cause irreparable harm [
9,
10].
Nitrifying bacteria are traditionally considered to be obligate aerobes; they require molecular oxygen for reactions in the N oxidation pathways and for respiration. They are reputed to be microaerophiles, however, who thrive best under relatively low oxygen conditions. Microaerophily may be important in interface environments such as the sediment–water interface and in the minimum oxygen zones of the ocean.
Ammonium is converted to nitrite, and subsequently to nitrate. The reaction mechanism is summarized in Equations (1) and (2):
Furthermore, some of the most significant contaminants associated with water bodies pollution are pathogenic microorganisms [
11]. It is also important to highlight that microbes are present everywhere and engage in complex interactions with a wide range of animals. They must be able to survive in a specific environment including water [
12], and they use various strategies to obtain the necessities for life. One of the prospective strategies to eradicate pathogenic bacteria from water bodies (especially on a small scale) is the use of antagonistic bacteria. A particular kind of bacterium produces substances called bacteriocins that have the ability to destroy other microbes with which they compete for resources [
13]. Therefore, bacteriocins can assist us in finding solutions to issues such as the elimination of pathogenic microbes from water [
14].
Depending on the type of protective wall they have, bacteria can be separated into two major groups: Gram-positive bacteria and Gram-negative bacteria [
15]. In principle, Gram-positive bacteria have a fairly thick cell wall, whereas Gram-negative bacteria have a considerably thinner one. Numerous bacteria frequently coexist and compete with one another for food, space, and other resources.
Members of the same species or members of different species may engage in this resource rivalry. Antagonizing methods are those employed by bacteria in their struggle for resources and space. A form of interspecies interaction is when one species gains by harming the other. Bacterial hostile tactics can take many different forms. They include eliminating crucial substances needed by rivals or altering the microenvironment to make it very difficult for other bacteria to survive. Antimicrobials made by bacteria are agents that prevent the growth of other microorganisms or kill them in order to stop the proliferation of their neighbors [
16].
Antimicrobials come in both specific and non-specific forms; when they take on any other bacterial rival, they do so without discrimination. Hydrogen peroxide (H
2O
2), the antiseptic for wounds, is one non-specific antibacterial. In contrast, specific antimicrobials are those that either eradicate or stop the development of a particular bacterial species. This implies that the rival bacteria manufacture weapons that are specifically designed to exploit each other’s weaknesses [
17]. We refer to a particular antimicrobial’s narrow spectrum of activity. As a result, some pathogens (bacteria that can harm humans, i.e., disease-causing bacteria) are effectively combatted by particular antimicrobials, which can aid in the fight against antibiotic-resistant superbugs, microbes with capacity to withstand the effects of an antibiotic that would have typically killed them [
18]. As bacteria adapt, antibiotics that once killed them or restricted their growth during an infection stop working. This is known as antibiotic resistance. Antibiotic-resistant pathogenic germs can then spread and cause a large number of fatalities. The particular antimicrobials, created by nature to exclusively kill the targeted harmful bacteria, can aid in the struggle against the threat posed by antibiotic resistance.
Antimicrobial proteins called bacteriocins are made by bacteria to kill other bacteria [
13]. Small proteins known as peptides generated by bacteria are the building blocks of bacteriocins [
19]. While some bacteriocins can remain affixed to the bacteria’s surface, others are completely discharged into the environment [
20]. Bacteriocins have unique geometries that they require in order to function and combat hostile microorganisms [
21]. Although the mechanism by which bacteriocins kill other bacteria is not fully known, it appears that bacteriocins make contact with other bacteria through receptor-like structures found on the surface of adversary bacteria [
22]. It functions in the same way as a key in a lock. The surface of the attacked bacterium generates tiny openings known as pores when bacteriocins bind to receptors and come into contact with the antagonistic surface. Through these pores, the bacterial cell’s contents flow out, killing the adversary microorganisms [
23].
Most bacteria are thought to be able to create bacteriocins; however, many of them are yet unknown to science. Additionally, little is known about the possibility of employing microorganisms to eradicate other pathogenic bacteria [
24]. Moreover, it is worth noting that microorganisms distributed in saltwater bodies play an important role in the decomposition of organic matter and mineralization. Therefore, screening of the most active bacteria with respect to these elements is relevant and cost-effective.
The study examines how bacteria can alter the mineral makeup of water while also having the power to eradicate other microbes. Using morphological, and biochemical methods and matrix-assisted laser desorption/ionization time-of-flight mass spectrometry (MALDI-TOF MS), five isolates were isolated from salt water and then identified. The phosphate solubilizing, nitrifying, and species-specific activities of the isolates were also established, in addition to their characterization and identification. As a result, all isolated strains were investigated and defined, and their impact on the concentration of minerals in water, such as phosphorus and nitrogen, was investigated. Future developments of bio-preparations with the potential for bioremediation in the removal of contaminants from various sources from polluted water bodies will be made possible by these investigations.
2. Materials and Methods
2.1. Case Study Description
Lake Big Saroba is a salt lake in the Akmola region, near the city of Nur-Sultan, and is located 50 km from the city (51°10′15″ North latitude and 72°5′32″ East longitude). To study the microorganisms of this lake, water samples were taken aseptically in sterile 500 mL glass bottles from different sampling points of the lake by directly dipping the bottles into the surface of the water. The samples were collected and preserved at 4 °C for transportation to the laboratory and microbiological analysis.
2.2. Microbiological Analysis. Isolation, Purification, Phenotypiccharacterization, and Identification of Bacterial Strains
Serial dilution techniques were used for the isolation of bacteria. From each dilution tube, 0.1 mL of dilution fluid was transferred into nutrient agar culture media and incubated at 37 °C for 24 h. The nutrient agar (NA) culture media contained 0.5% peptone, 0.3% yeast extract, 0.5% NaCl, 0.25% glucose, 1.5% agar, and distilled water, and the pH was adjusted to 7 at room temperature. Colonies were purified by twice subculturing using the streaking plate method. Young cultures were used for Gram staining. After Gram staining, samples of bacterial culture were observed under a microscope and characterized. The cultural and biochemical properties of the isolates were studied by inoculation onto a common medium and their subculture on media to reveal their different properties in relation to other microorganisms and chemical compounds. Antibiotic susceptibility was determined by the disk diffusion method using available antibiotics: penicillin, tetracycline, roxithromycin, kanamycin, ampicillin, amoxicillin/clavulanic acid, clindamycin, cefazolin, gentamicin, vancomycin, carbenicillin, fusidine, oleandomycin, rifampicin, neomycin, oxacillin, ciprofloxacin, erythromycin, and chloramphenicol.
2.3. Determination of the Biochemical Activity of Isolates
For the determination of lipolytic activity, the studied microorganisms were sown on a medium containing the corresponding oleic acid. To study the amylolytic activity, we used the plaque method on a medium of the following composition (g/l): peptone, 10.0; KH2PO4, 5.0; soluble starch, 2.0; and agar, 15.0. The medium pH was 6.8–7.0. Sowing was carried out by injection. The starch hydrolysis zone was measured in millimeters from the edge of the colony stroke to the border of the light zone. The larger the diameter of the light zone, the higher the amylolytic activity. For determination of saccharolytic activity, microorganisms were differentiated according to their ability to decompose carbohydrates by fermentation. Sugar fermentation ability was studied by cultivation in Andrade’s indicator medium and available carbohydrate disks such as arabinose, cellubiose, dextrose, galactose, fructose, lactose, maltose, mannose, mannitol, xylose, rhamnose, etc. The test strain and disks with carbohydrates were placed in test tubes with a sterile Andrade medium.
Phosphate breakdown processes from the metabolism of phosphate-dissolving bacteria usually occur with the release of organic acids from carbon sources such as glucose by direct oxidation. The hydroxyl and carboxyl groups then chelate with cations in phosphate minerals such as Ca, Fe, and Al, releasing soluble phosphate. For the determination of phosphatase activity, bacteria dissolving calcium orthophosphates were detected on Muromtsev’s medium. Calcium phosphates, Ca
3(PO
4)
2, were introduced into the nutrient medium by the precipitation method proposed by Gerretsen [
25]. Quantitative analysis of the solubilizing activity of phosphates on an agar medium was evaluated by the diameter of the clearing zones. The clearing zones formed by the bacteria on the respotted plates were quantified on the 4th day of incubation using the equation below:
Phosphorous solubilization on a solid medium was measured in terms of solubilization efficiency (SE):
where Z is the solubilization zone and C is the colony diameter.
To determine the nitrifying activity, namely, the ability of microorganisms to utilize organic and mineral forms of nitrogen, the presence of growth or signs of their development was determined on synthetic media from which all nitrogen sources were excluded, except for the tested nitrogen sources. When ammonifiers were detected, peptone was added to the main composition of the synthetic medium. For denitrifiers, NaNO3 was added, and NH4Cl and CaCO3 were added to the media of nitrifying bacteria. Media of the same composition without nitrogen (negative control) and a medium with ammonium sulfate as a source of nitrogen (positive control) were used as controls.
2.4. Antimicrobial Susceptibility Testing
The entry of biological agents into aquatic systems can pose a serious public health hazard because these agents cannot be easily detected and may remain hidden until widespread contamination occurs. The search for new antimicrobial agents is a field of utmost importance. The prevalence of antimicrobial resistance among key microbial pathogens is increasing at an alarming rate worldwide. The antagonistic activity of bacteria is carried out with the help of different (often very subtle) molecular mechanisms, and its manifestation depends on a number of factors, among which, first of all, the variety of interactions between the antagonist and its victim in specific environmental conditions should be mentioned. In the first stages of the study, mainly in vitro methods were used, allowing us to eliminate non-active or low-active strains that were not of interest. The diffusion method with wells is based on the diffusion of antibiotic substances formed by the test isolates into the thickness of the agar medium containing the test culture and suppressing the growth of the latter. The agar medium used must ensure good growth of both the bacterial strain under the test and the test strain. This method enables the simple and rapid checking of a large array of bacterial strains and/or test cultures of unwanted microbes (sanitary indicative, pathogenic, or technically harmful).
Therefore, we analyzed isolated microorganisms regarding antagonistic activity against bacterial strains such as Enterococcus feacalis, Escherichia coli, Staphylococcus aureus, Salmonella enteritidis, Pseudomonas aeruginosa, Pseudomonas taiwanensis, Aeromonas punctata, Klebsiellapneumonia, which are in the collection of industrial microorganisms of the Republican Microorganism Collection.
Pathogenic bacteria were cultivated on plates with Mueller–Hilton agar nutrient medium at 37 °C for 24 h. Suspensions of pathogens were prepared from one-day cultures in sterile distilled water. Using a Biosan DEN-1B densitometer, the suspension density was adjusted to 2.5 McFarland (approximately 108–109 CFU mL−1). After preparing a tenfold dilution of 0.1 mL with a final concentration of 106 CFU mL−1, it was massively inoculated onto plates with a nutrient medium. After drying the surface of the plate, 10 μL of a cell suspension prepared from isolates (containing about 106 cells) was applied to agar wells. The plates were incubated at 37 for 24 h. By measuring the diameter of the clear zone around the wells where opportunistic and pathogenic cultures did not grow, the hostile activity of the isolated bacteria was calculated.
For the identification of these isolated bacteria, their one-day pure cultures were identified by the MALDI-TOF MS analyzer. [
26]. Using a toothpick, the colonies that developed in the solid medium were collected. Then a thin layer was applied to the target plate. Identification reliability was assessed on a scale from 0 to 3: scores < 1.7 were considered unreliable identification, scores from 1.7 to 2.0 were for identification at the genus level, and >2.0 indicated identification at the species level.
2.5. Statistical Methods
2.5.1. Parameters’ Correlation
The associations between colony diameter, colony diameter + clearing zone, solubilization index, and solubilization efficiency (%) were crucial characteristics that were determined by calculating the correlation indices. The degree to which the selected parameters were correlated with one another was significantly influenced by these indices. According to the indices, a high correlation often indicated that two or more variables were closely related to one another. If there was only a weak correlation between the variables, there was no meaningful association between them. The associations were rated as “bad,” “moderate,” “strong,” and “very strong”, which corresponded to the scores 0.3–0.49, 0.5–0.69, and 0.7–1, respectively [
27].
2.5.2. Data Distribution Analysis
The data distributions among the specified parameters of interest (colony diameter, colony diameter + clearing zone, solubilization index, and solubilization efficiency (%)) were evaluated using box and whisker diagrams. Data quartiles, often referred to as percentiles and averages, were used to evaluate the distribution of the data based on the skewness of the numerical data [
28].
2.5.3. Analysis of Variance
To assess the statistical significance of the variations in the investigated parameters (colony diameter, colony diameter + clearing zone, solubilization index, and solubilization efficiency (%)), a single-factor Analysis of Variance (ANOVA) was carried out in this work. Using samples from each group of data, the approach assesses the degree of variation within each group. The significance level was evaluated using the difference between the
p-value and alpha (0.05) values. The alpha number, which measures the chances of rejecting the null hypothesis, even if it is correct, must also be considered. Moreover, if the
p-value is greater than the alpha, the null hypothesis is accepted. The
p-value, on the other hand, indicates the likelihood of obtaining a result that is more extreme than the experiment’s outcome [
29].
2.5.4. Tukey’s Honest Significance Test
Furthermore, the study also made use of Tukey’s Honest Significance Test to evaluate whether there were any statistically significant differences from the means of the parameters under consideration (colony diameter, colony diameter + clearing zone, solubilization index, and solubilization efficiency (%)) [
30].
4. Discussion
As was previously mentioned, this study involved the isolation and characterization of bacterial strains from Big Saroba Lake. Five distinct bacterial strains were discovered in culture media: BS-1, BS-2, BS-3, BS-4, and BS-5. These were identified as
Shewanella baltica,
Arthrobacter histidinolonovorans,
Arthrobacter histidinolonovorans, Pseudomonas extremorientalis and
Halomonas aquamarina respectively. It is important to remember that phenotypes are the observable traits of an organism. These phenotypes for bacteria frequently involve growing on particular media, such as those with various carbon sources. According to the findings, the rods BS-1, BS-4, and BS-5 are Gram-negative, whereas BS-2 and BS-3 are Gram-positive. All of the isolates’ colonies were spherical and had yellow-red, yellow, and off-white coloring. Isolate BS-4 exhibited the strongest resistance to antibiotics, whereas isolates BS-2 and BS-1 had the highest sensitivity, according to tests of isolate susceptibility. In the study, the BS-1 isolate was found to be resistant to penicillin, amoxicillin/clavulanic acid, oxacillin, fusidine, and rifampicin. Among all the tested antibiotics, the BS-2, BS-3, and BS-5 isolates were only resistant to oxacillin. The BS-4 isolate was resistant to fusidine, oxacillin, tetracycline, and penicillin. Antimicrobial resistance occurs when bacteria, fungi, and other microorganisms learn to resist the medications meant to kill them, implying that the germs survive and develop. Treatment for resistant infections can be challenging and perhaps impossible. It is emphasized in the literature that by 1942 when four
Staphylococcus aureus strains were discovered to be penicillin-resistant in hospitalized patients, the spread of penicillin resistance had already been confirmed [
46].
The majority of the discovered isolates were not resistant to kanamycin, ampicillin, gentamicin, carbenicillin, neomycin, ciprofloxacin, erytromicin, levomicin, or cefazolin, even though all of the identified isolates were resistant to oxacillin. Various biochemical tests were conducted on the five isolates. Proteolytic activity was evident in isolates BS-2 and BS-3, with casein hydrolysis zones measuring 9.30.48 and 8.00.58, respectively. Of the five detected bacteria, the isolates BS-1 and BS-5 both tested positive for lipase. However, none of the strains had the ability to hydrolyze starch. Starch, a mixture of amylose and amylopectin, gives non-photosynthesizing lifeforms a way to use the energy from the sun in addition to acting as a food store for plants. The presence of enzymes that catalyze the hydrolysis of the (l→4) glycosidic linkages found between the α-D-glucopyranose residues is necessary for the use of starch by organisms. Amylases are enzymes made by plants, microorganisms, and animals that are capable of catalyzing the hydrolysis of α-D-(l→4) links. Isoamylases, also known as debranching enzymes, hydrolyze the α-D-(l→6) links of amylopectin, in addition to amylases [
47].
The screening of sugar fermentation was performed using pre-made, commercial disks that contained different sugars. Three isolates could break down different types of carbohydrates by fermentation with varying degrees of activity. The carbohydrate fermentation test can be used to determine whether or not bacteria are capable of fermenting a certain carbohydrate. It checks for the presence of any gas or acid that was released during the fermentation of a certain carbohydrate.
Additionally, the results of the Big Saroba Lake isolates’ saccharolytic activity revealed that isolate BS-1 had the highest level of saccharolytic activity for a variety of sugars, including arabinose, cellubiose, dextrose, galactose, fructose, lactose, maltose, mannose, mannitol, xylose, and rhamnose. It is important to note that saccharification is the procedure used in the manufacture of ethanol fuel to separate complex carbohydrates such as corn or sugar cane into their monosaccharide components. During mashing, the third stage in the production of starch ethanol takes place. In contrast to isolate BS-1, isolate BS-2 was able to ferment galactose but lacked the enzymatic capacity to break down fructose, mannose, or xylose; isolate BS-3 showed the same capacity to ferment galactose as isolate BS-2, but unlike isolate BS-1, it lacked the enzymatic ability to break down arabinose, mannose, or mannitol. However, the BS-4 and BS-5 strains were unable to ferment carbohydrates. Short-chain fatty acids and a range of other metabolites, including the electron-sink products lactate, pyruvate, ethanol, H, and succinate, are created when saccharolytic bacteria digest carbohydrates in the large intestine for enhanced energy and development. While facultative anaerobes are much less common than obligatory anaerobes, the bulk of the big gut microbes in humans has a purely anaerobic metabolism [
48].
Three of the five isolates, BS-2, BS-3, and BS-4, produced positive results for the qualitative assessment of the phosphate solubilizing activity of the isolates. It is also important to keep in mind that phosphate solubilizing microbes are a class of helpful microorganisms that can hydrolyze organic and inorganic insoluble phosphorus compounds into soluble phosphorus forms that are readily digested by plants [
49]. Additionally, these vast microflorae have an important role in the mineralization of organic phosphorus, the solubilization of inorganic phosphorus minerals, and the storage of enormous amounts of phosphorus in biomass. They mediate the bioavailability of soil phosphorus [
50]. However, the quantitative study revealed that among these three isolates, the BS-4 isolate had the highest efficiency. The BS-4 isolates’ phosphate-solubilizing activity efficiency was up to 100%, which was higher than the activities of BS-2 and BS-3 with roughly 78 and 69%, respectively. The indices of solubilization activity for these isolates were also calculated, and they were found to be 1.80 ± 20 for BS-2, 1.70 ± 07 for BS-3, and 2.20 ± 28 for BS-4. It is stated in the study by Kirui et al. [
51] on diversity and phosphate solubilization efficiency that interactions with other microorganisms are one of the variables influencing phosphate solubilization.
Examining the isolates’ nitrifying abilities was another crucial component of the investigation. Additionally, it is critical to realize that nitrification plays a crucial role in the biogeochemical nitrogen cycle and in biological wastewater treatment. Ammonia oxidation by ammonia-oxidizing bacteria or archaea and nitrite oxidation by nitrite-oxidizing bacteria are the two sequential processes that make up this process [
52]. Historically, research utilizing pure representative strains has been used to characterize the biochemical and physiological characteristics of ammonia-oxidizing bacteria. The majority of nitrifying microorganisms, however, are challenging to isolate and cultivate using traditional culture-based techniques. Cultivation-independent molecular methods have revealed a high diversity and predominance of members of this group of microorganisms that have not yet been cultured [
53]. Based on the results, isolates BS-2 and BS-3 demonstrated the highest levels of similar nitrifying activity, and isolates BS-1 and BS-4 had limited nitrifying activity. Isolate BS-5 was unable to ingest organic or nitrate nitrogen forms. Because they need molecular oxygen for activities in the N oxidation pathways and for respiration, nitrifying bacteria are traditionally thought of as obligatory aerobes. However, they are thought to be microaerophiles that grow best in environments with little oxygen. Microaerophily might be significant in ecosystems with interfaces, such as the sediment–water interface and the ocean’s oxygen-minimum zones [
54]. Two steps are required for nitrifying bacteria to convert ammonia (NH
3) to nitrate (NO
3). First, the ammonia-oxidizing bacteria convert ammonia to nitrite (NO
2), and second, the nitrite-oxidizing bacteria convert nitrite to nitrate [
55].
The investigation into the detected isolates’ probable antagonistic behavior was another focus of the study. Microbial antagonism is the process whereby one type of bacterium stops another from developing. It may occur because of competition for resources between the two organisms or because one microorganism releases a substance that is harmful to the other. In this context, we first considered the antibiotic effect of isolated bacteria. The BS-5 isolate stood out for having antagonistic activity, which did not manifest against
Salmonella and
Klebsiella but did against other bacteria. It also exhibited a high sensitivity to medications, which is advantageous from a clinical standpoint. While the isolate BS-3 solely exhibits antagonistic activity toward
Staphylococcus aureus, BS-1 and BS-2 lacked any antagonistic activity. The ability of
Staphylococcus aureus to develop antibiotic resistance is well known. Antibiotic-resistant strain infections frequently occur in epidemic waves that are started by a single or a small number of successful clones. Methicillin-resistant
Staphylococcus aureus is a common strain throughout these epidemics, according to Chambers and DeLeo [
56], who looked into the waves of resistance in
staphylococcus aureus in the antibiotic era. In addition, according to the research by Amer et al. [
57], some bacterial species found in the cockroach gut were able to inhibit the growth of all the pathogens that were tested.
5. Conclusions
To examine various microbial potentials, a selection of active microbial strains was isolated from water samples of a naturally salty lake. Based on a Maldi analysis, five bacterial isolates BS-1, BS-2, BS-3, BS-4, and BS-5 were identified as Shewanella baltica, Arthrobacter histidinolonovorans, Arthrobacter histidinolonovorans, Pseudomonas extremorientalis and Halomonas aquamarine, respectively. It was observed that isolates BS-1, BS-4, and BS-5 did not have nitrifying activity, isolates BS-1, and BS-5 did not have phosphate solubilizing activity, and isolates BS-2, BS-3, and BS-4 had phosphate solubilizing activity. Additionally, isolates BS-2 and BS-3 expressed nitrifying activities. In summary, isolates BS-2, BS-3, and BS-4 have a significant effect on the cycling of phosphorus and nitrogen in nature. Regarding the antagonistic activity of the isolates toward opportunistic microbiota in water, isolates BS-3, BS-4 and BS-5 showed the highest activity in comparison with the others. As a result, isolates BS-2, BS-3, BS-4, and BS-5 (all except isolate BS-1) were placed in long-term storage. In summary, among the studied isolates, the BS-4 (Pseudomonas extremorientalis) isolate showed the most promising value in phosphate solubilizing, nitrifying, and antagonistic activities. These findings provide useful information for developing appropriate biological products in water treatment. Further research should focus on investigating the effectiveness of these isolates, either alone or in combination with each other, for their phosphate solubilizing and nitrogen-fixing capabilities in the bioremediation of water bodies, especially sewage ponds.